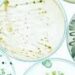
भारत सरकार ने उर्वरक नियमों का विस्तार कर नए बायोस्टिमुलेंट और माइक्रोबियल फॉर्मूलेशन को शामिल किया

֍:केस का पृष्ठभूमि
§ֆ:आरोप है कि अब्बास अंसारी ने एक सार्वजनिक सभा में धर्म और समुदाय के आधार पर भड़काऊ बयान दिए थे, जिससे सामाजिक सौहार्द बिगड़ने का खतरा पैदा हुआ। इस पर गाज़ीपुर पुलिस ने उनके खिलाफ केस दर्ज किया और कोर्ट में चार्जशीट पेश की।
§֍:कोर्ट का फैसला
§ֆ:गाज़ीपुर की एक अदालत ने अब्बास को भारतीय दंड संहिता (IPC) की धारा 153A (सामुदायिक तनाव फैलाना) के तहत दोषी ठहराया है। अदालत ने उन्हें 2 साल की जेल और 3000 रुपये का जुर्माना लगाया है। हालांकि, उन्हें तुरंत गिरफ्तार नहीं किया गया है, क्योंकि उन्हें अगले 30 दिनों के भीतर हाईकोर्ट में अपील करने का अवसर दिया गया है।
§֍:अब्बास की राजनीतिक स्थिति
§ֆ:अब्बास अंसारी उत्तर प्रदेश के मऊ सीट से विधायक हैं और उनके पिता मुख्तार अंसारी, जो खुद कई आपराधिक मामलों में जेल में हैं, पहले भी विधायक और सांसद रह चुके हैं। इस सजा के बाद अब्बास की विधायकी पर भी सवाल उठ सकते हैं, क्योंकि दो साल से अधिक की सजा होने पर संविधान के अनुसार उनकी सदस्यता रद्द हो सकती है।
§֍:प्रतिक्रियाएं§ֆ:इस फैसले के बाद विपक्षी दलों ने सरकार पर चुनावी दबाव बनाने का आरोप लगाया है, जबकि सत्तारूढ़ पार्टी के नेताओं ने कहा है कि कानून सभी पर समान रूप से लागू होता है।
अब्बास अंसारी की टीम ने कहा है कि वे हाईकोर्ट में इस फैसले को चुनौती देंगे। अगले कुछ दिनों में इस मामले में और विकास होने की उम्मीद है।
§गैंगस्टर-राजनेता मुख्तार अंसारी के पुत्र और मौजूदा विधायक अब्बास अंसारी को हेट स्पीच (सामुदायिक विद्वेष फैलाने) के एक मामले में 2 साल की कैद और 3000 रुपये के जुर्माने की सजा सुनाई गई है। यह मामला 2020 का है, जब अब्बास पर आपत्तिजनक भाषण देने का आरोप लगा था।